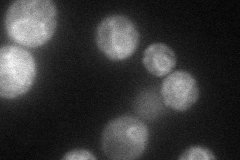
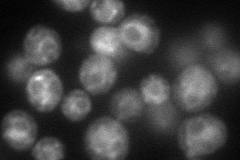
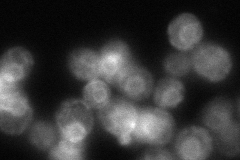
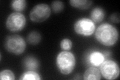

View description
Evolutionarily conserved protein with similarity to Orm1p, required for resistance to agents that induce the unfolded protein response; human ortholog is located in the endoplasmic reticulum
Localization:
Intensity:
Fold change:
Significance:
-
C’ GFP library in SD

ER37.6 -
N' NOP1pr-GFP in SD
ER52.7537 -
N' TEF2pr-mCherry in SD
ER,vacuole78.8444 -
N' NATIVEpr-GFP in SD
ER79.0608 -
N' TEF2pr-VC and Cyto-VN in SD

#N/A0 -
C’ GFP library in SD+DTT
ER120.863.21Yes -
C’ GFP library in SD+H2O2

ER33.510.89No -
C’ GFP library in Starvation Media

ER48.91.3No -
C’ GFP library on the background of Pup2-DaMP

N/A -
C’ GFP library on the background of CCT mutant

N/A0N/AYes
